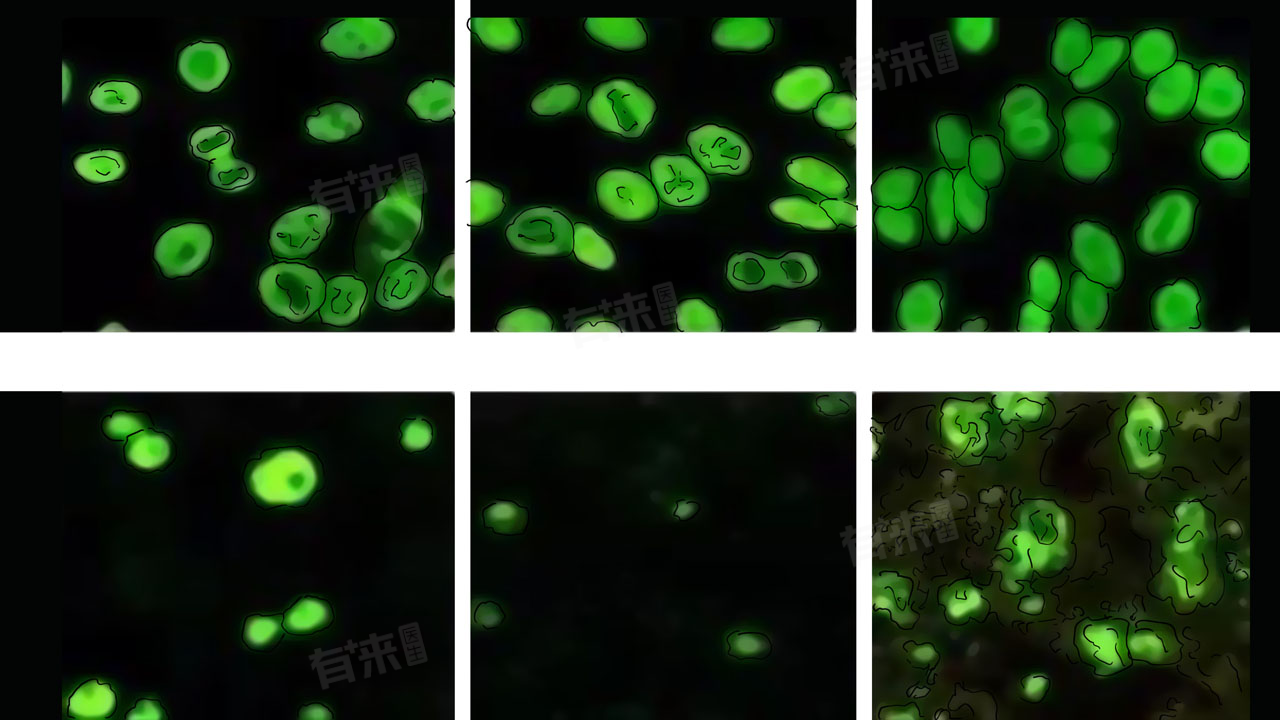

单纯依靠类风湿因子的数值升高,并不能直接确诊类风湿关节炎,类风湿因子高多少定为类风湿并没有一个绝对的标准。正常人的类风湿因子水平通常较低,多在0-20IU/ml。但类风湿因子升高到一定程度,如超过正常上限的两倍甚至更高,可能提示患有类风湿关节炎的风险增加,但这并不是确诊的唯一依据。
- 类风湿因子阳性可见于多种情况。除了类风湿关节炎,还可见于其他自身免疫性疾病,如干燥综合征、系统性红斑狼疮、硬皮病等;某些感染性疾病,如慢性肝炎、结核等;甚至在老年人中,也可能出现类风湿因子低度阳性,所以并不能只靠该指标确诊类风湿关节炎。
- 在诊断类风湿关节炎时,医生会综合考虑患者的临床症状、体征、实验室检查以及影像学结果等多方面的因素。典型的类风湿关节炎症状包括对称性的多关节肿胀、疼痛、僵硬,尤其是手指、手腕等小关节受累更为常见。晨僵现象通常较为明显,持续时间较长。
- 实验室检查除了类风湿因子外,还可能会检测抗环瓜氨酸肽抗体(抗CCP抗体)、红细胞沉降率(ESR)、C反应蛋白(CRP)等指标。抗CCP抗体对类风湿关节炎的诊断具有较高的特异性。
影像学检查,如X线、磁共振成像(MRI)等,可以帮助医生观察关节的结构变化,如关节间隙狭窄、骨质破坏等。在疾病的早期阶段,有时各项检查结果可能不典型,这给诊断带来了一定的困难。对于高度怀疑类风湿关节炎但诊断依据不足的患者,医生可能会建议定期复查、密切观察病情变化,以便及时明确诊断。

